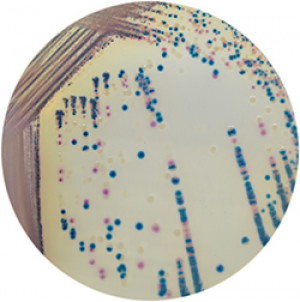

Performance
Polymyxin E (colistin) and B are increasingly used as antimicrobials in the treatment of multi-drug resistant bacterial infections. Polymyxin resistance, although intrinsic in Gram-positive and some Gram-negative species (Proteus, Morganella, Serratia), is now a problem in a number of other pathogens(Acinetobacter baumannii, Pseudomonas aeruginosa, Escherichia coli, Salmonella enterica, Klebsiella pneumoniae).*
Resistance arises due to mutations/insertions in genes involved in LPS biosynthesis (lpx, pmrA/B, mgrB, phoP/Q) and/or the acquisition of phosphoethanolomine transferases (PEtN).Of great concern is the recently described plasmid-encoded PEtN, MCR-1, now found worldwide in a range of animal, human and environmental bacterial isolates.*
CHROMagar™ COL-APSE is a sensitive and specific medium for the growth of Colistin resistant bacterial pathogens with a lower limit of detection of 10 CFU/mL. This new chromogenic medium may be useful as a primary isolation medium in the surveillance and recovery of Colistin resistant bacteria from complex human, veterinary and environmental samples especially those with plasmid mediated MCR-1 or novel mechanisms of polymyxin resistance.*
* Novel Chromogenic Culture Media (CHROMagar™ COL-APSE) for the Isolation and Differentiation of Colistin Resistant Gram-negative Pathogens. Muhd Haziq F Abdul Momin, David W Wareham. ECCMID 2017.
Intended Use:
CHROMagar™ COL-APSE is a selective and differential chromogenic culture medium, intended for use in the qualitative direct detection of gastrointestinal colonization with colistin-resistant Gram-negative bacteria (COL-R) to aid in the prevention and control of COL-R in healthcare settings. The test is performed with rectal swab, perineal swabs and stools samples from patients to screen for COL-R colonization. Results can be interpreted after 18-24 h of aerobic incubation at 35-37 °C.